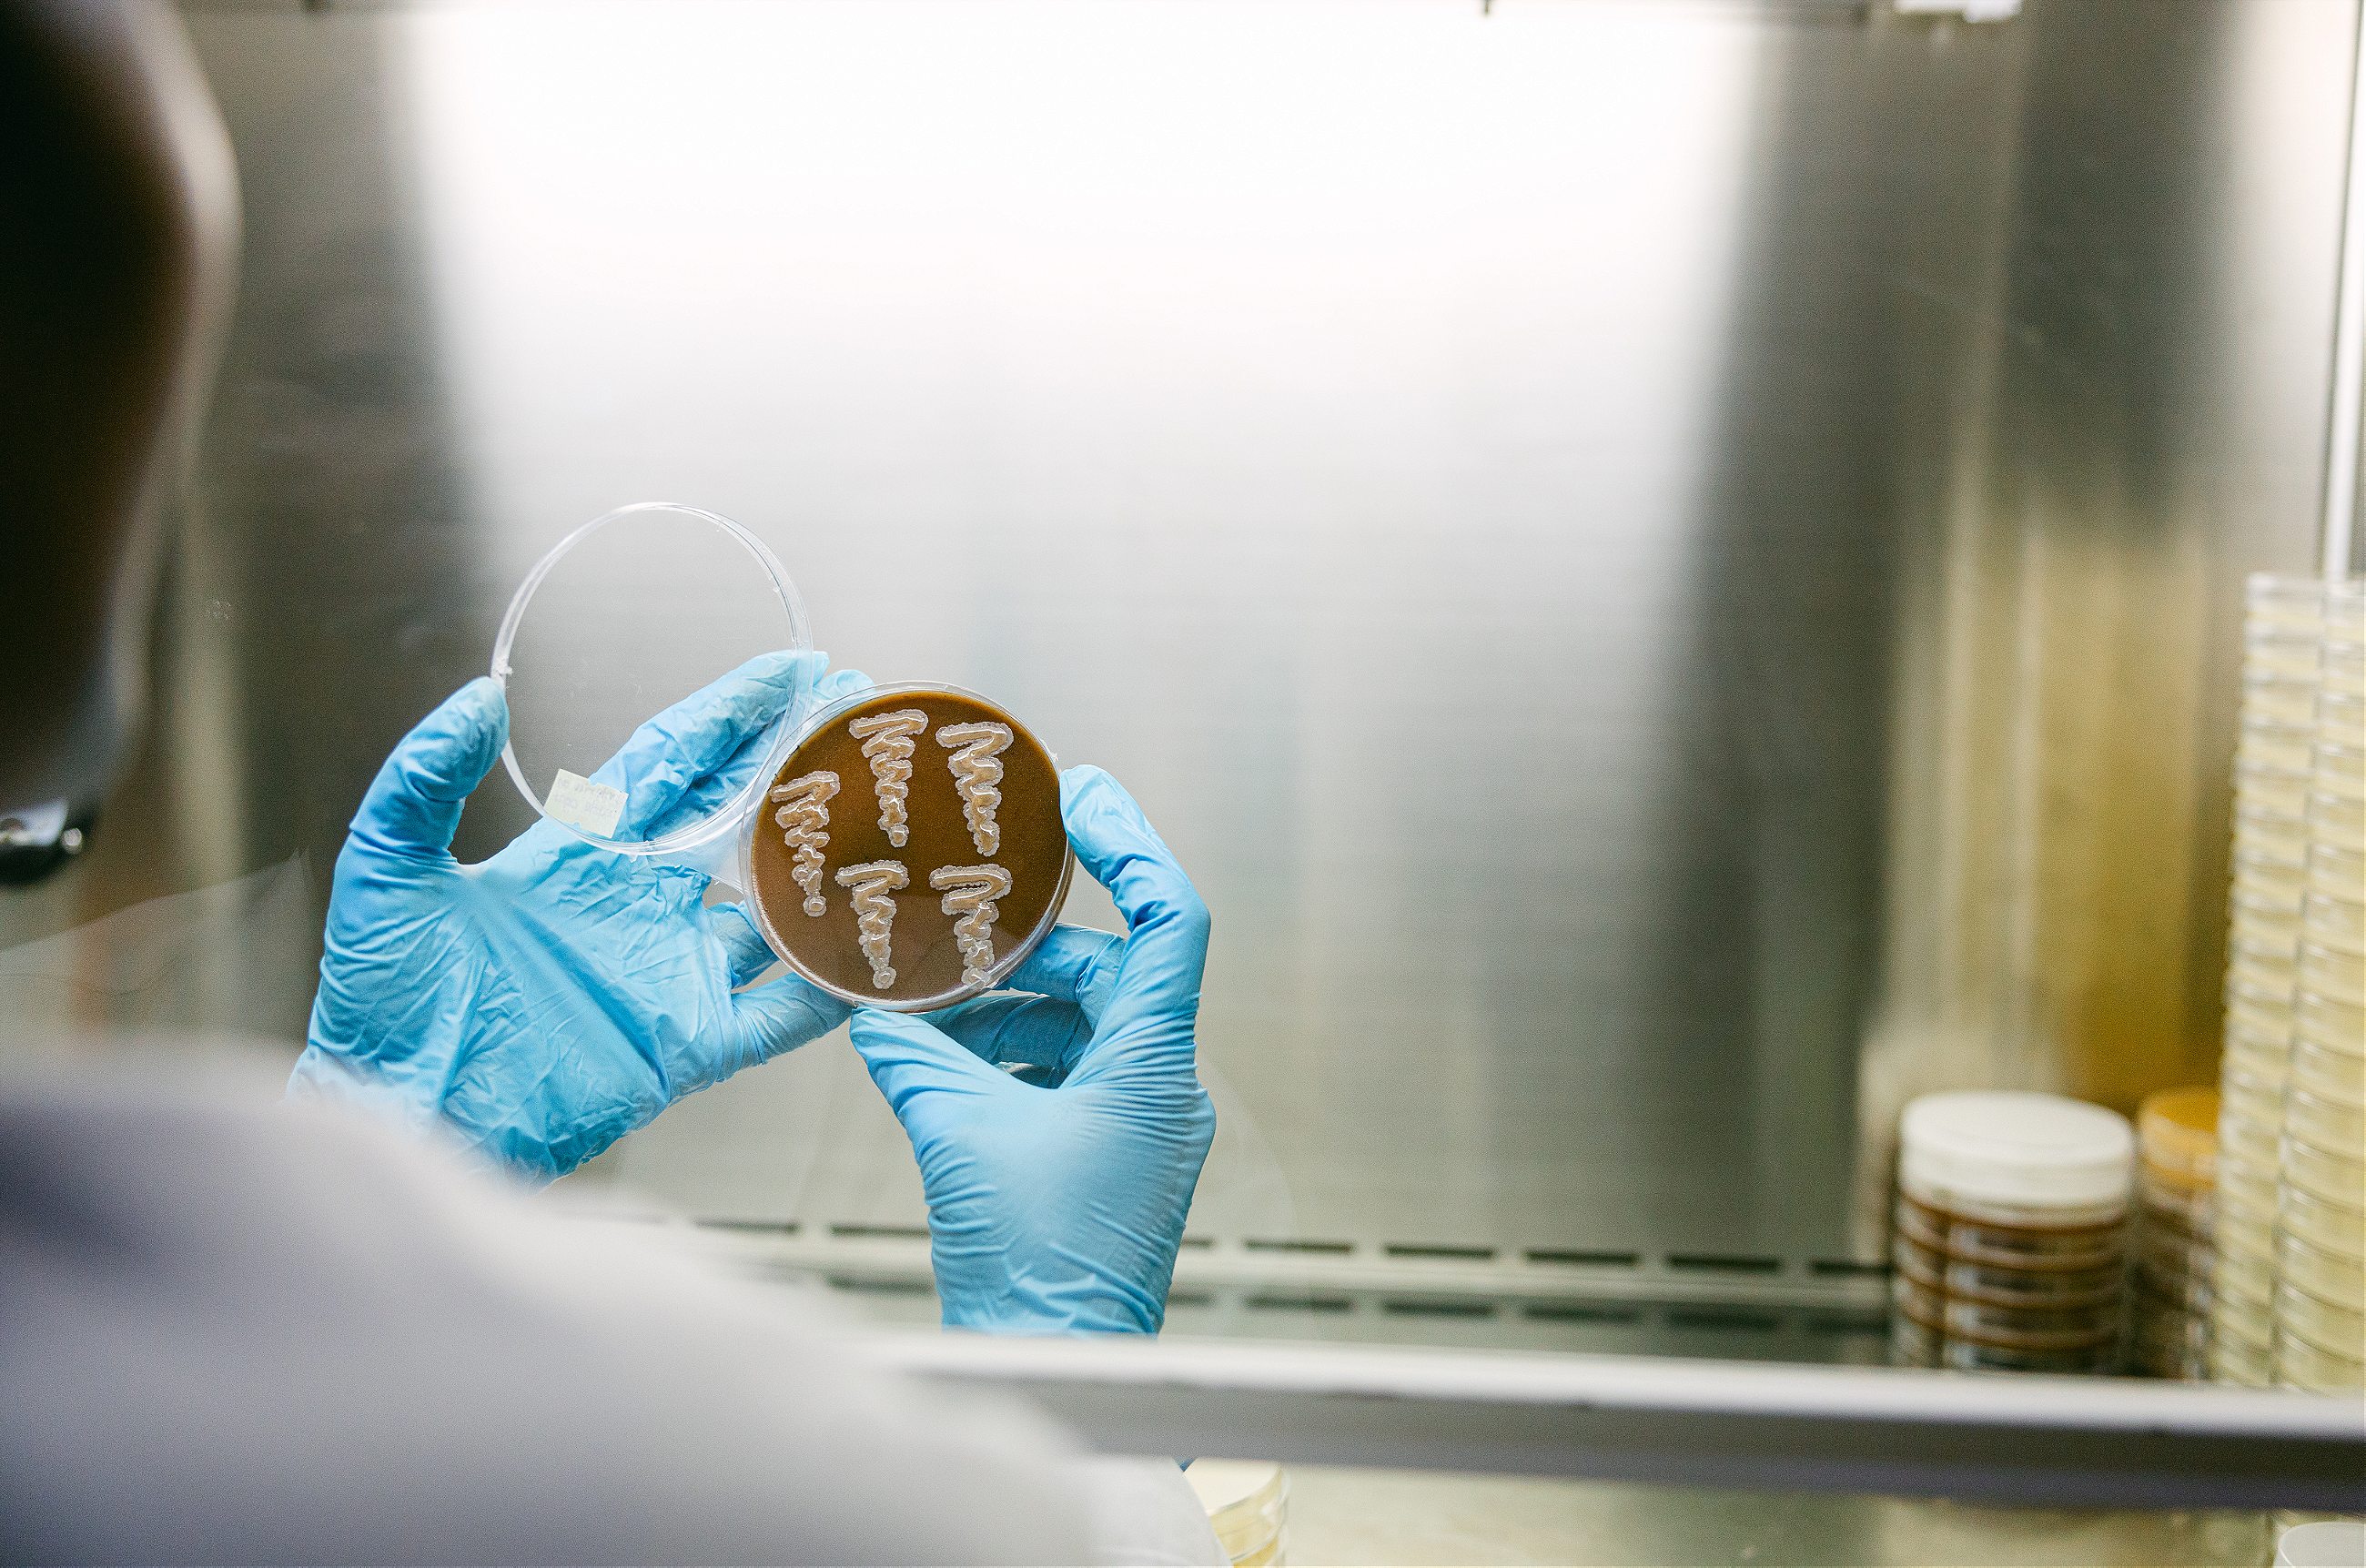

In Tanzania, NovFeed is transforming the country’s compost into a source of cheap and nutritious feed for farmed fish. NovFeed is a finalist for the 2024 Food Planet Prize.
DAR ES SALAAM, Tanzania –
When Diana Orembe was growing up in Northern Tanzania, her uncle worked as a fish farmer. It was a difficult profession, where high costs and low profit margins were the norm. He put a lot of money into the fish farm, but expensive fish feed meant minuscule returns. Orembe’s uncle tried to reduce the money spent on feed but didn’t have any real alternatives. The only other option was to feed the fish a diet of rotting vegetables and chicken droppings, but fish fed this way took a long time to reach market size—and he had a growing family to feed.
When Orembe joined the University of Dar-es-Salaam to study microbiology, she kept returning to her uncle’s problem, and to the plight of fish farmers like him. In addition to the cost of the feed, the efficiency of available fish feed products concerned her. They were made from either dagaa, a fish consumed widely in Tanzania, or soybean, another common food for Tanzanians. Both inputs were problematic. There were questions about the ethics of using a wild fish like dagaa to feed farm-grown fish. Plus, removing wild dagaa from their lakes has far-reaching, damaging repercussions on their ecosystem. Soybean farming is land-intensive, requiring extensive arable land and water to produce enough feed for all the country’s fish farmers.


At the end of 2019, Orembe attended a workshop with two other scientists trying to solve Tanzania’s fish feed problem: Otaigo Elisha, who studied Natural Resource and Environmental Economics and Innocent Lymo, who had a master’s degree in Aquaculture Science. They were excited to meet others working to solve the same issue. Soon after the workshop, they travelled to different parts of the country, talking to fish farmers who told them that their biggest problem was finding fish feed that was not only cheap, but also efficient. The three of them decided to start a solutions-oriented company. With NovFeed, they believed they could create a new kind of fish feed that would be affordable for farmers, efficient in its production method, and cause minimal impact on the fish. And the unlikely key to all of this? Tanzania’s garbage.
Dar-es-Salaam produces a lot of waste—roughly 9000 metric tons every day, 70% of which is organic waste. This is approximately the same amount as Kinshasa, one of Africa’s largest cities, despite the latter having a population double that of Dar-es-Salaam. “If we don’t take action now, Dar will be the town with the most waste in East Africa in ten years,” Orembe says.

NovFeed’s fish feed is made from some of this waste, particularly fruit. Every week, the company collects fruit waste from markets across Dar. That waste is then transported to the NovFeed site in Kibamba, roughly thirty kilometres from the city centre, with offices, a waste sorting area, a fermentation lab, an extractor for drying the feed, and storage rooms. A corridor of tall green tree ferns welcomes one into the compound, though the ferns do little to mask the pungent smell of fermentation. Arrayed around NovFeed’s compound are the bright iron sheet roofs of nearby villages, and in the middle of the compound are shelves for storing the waste fruit collected from the markets in the city. There are discarded pineapples, avocados, bananas, mangoes, eggplants, and whatever other fruits are in season at a given time. The fruit must dry completely before it can be processed. Instead of using electricity, NovFeed employees dry them in the sun. On a late January visit to the facility, swarms of bees hovered over the drying fruit, attracted by the sugary scent.

Once dried, the fruit is taken into the lab. There, it’s mixed with a lactic acid bacteria to induce fermentation. There are specific kinds of bacteria which are used to break down the dried fruit into biomass which will be used as the feed, and in the lab a team of scientists isolates the bacteria that will do the fermentation. The faster the fermentation process, the cheaper the feed is to produce. To ensure that the fermentation can be done as quickly as possible (between 56-72 hours), a concoction of five specially chosen microbes is used in the fermentation. The microbes have been tested to make sure they are compatible with each other. The NovFeed team changes the combination of microbes often, as they experiment to see which ones produce a faster rate of fermentation.
After fermentation, the resultant biomass is placed in an extractor to produce floatable pellets. Most fish farmers in Tanzania grow tilapia, which eat food on the water’s surface. The pellets are then dried to prohibit fungi growth that would render the feed unusable. NovFeed produces pellets in four different sizes to be eaten by fish at different stages of maturity, whether tiny fingerlings or full-grown tilapia that are almost at market size.
Pellets are tested on fish at the NovFeed plant before being sold to farmers. Next to the racks of drying fruit are three fishponds, each with a different environment. These diverse ponds are meant to mimic the water conditions fish farmers must contend with. Elisha says, “When we advise farmers, we have to advise them based on the parameters we have.”
In the ponds, NovFeed scientists test the water quality as well as the growth rate of the fish. Education is an important part of their sales pitch: Before a farmer signs up to use their feed, NovFeed sends a scientist to explain to them how the feed works, and how to use it. After the farmer joins the NovFeed program, the company continues to provide support. Over a few months, they collect information from the farmers about their process — how the fish are responding to the feed, the kind of water used in their fish farms, where the farmers get their fingerlings from. This collection aims to find out what the farmers need to tweak in order to achieve optimum growth conditions for the fish.


Pellets are tested on fish at the NovFeed plant before being sold to farmers. Next to the racks of drying fruit are three fishponds, each with a different environment. These diverse ponds are meant to mimic the water conditions fish farmers must contend with. Elisha says, “When we advise farmers, we have to advise them based on the parameters we have.”
In the ponds, NovFeed scientists test the water quality as well as the growth rate of the fish. Education is an important part of their sales pitch: Before a farmer signs up to use their feed, NovFeed sends a scientist to explain to them how the feed works, and how to use it. After the farmer joins the NovFeed program, the company continues to provide support. Over a few months, they collect information from the farmers about their process — how the fish are responding to the feed, the kind of water used in their fish farms, where the farmers get their fingerlings from. This collection aims to find out what the farmers need to tweak in order to achieve optimum growth conditions for the fish.

According to research undertaken by NovFeed, their feed has thus far proven more efficient than feed made from soybean and dagaa. NovFeed has a higher protein content (over 70% as compared to 50% for the dagaa feed and 45% for the soybean feed), and a much quicker production time (3 days, as compared to 3 months for soybean and 2 months for dagaa). While Orembe’s uncle has since passed away, his spouse—her aunt—is still a fish farmer. She’s one of 72 farmers signed up to NovFeed’s program. The farmers are located in different parts of the country, some along the coast near Dar es Salaam, others as far out as Dodoma, the country’s capital, 400 kilometres away. Transportation is currently a challenge: NovFeed doesn’t have its own distribution network yet, so they send the farmers the bags of feed via public buses.
Now, their aim is to scale up their product and get more farmers signed up. Elisha is bullish about the size of their potential market, pointing out that while the fish feed market in Tanzania so far is valued at $240 million USD, NovFeed aims to provide as much as $25 million USD worth of feed to the country by 2030. A huge driver behind his optimism is the Tanzanian government’s interest in increasing fish consumption in the country in order to increase the nutrition levels of its citizens. Currently, the average person in Tanzania consumes 8kg of fish per year, far below the recommended consumption rate of 20kg per person.


The national government wants to increase the consumption rate to 10kg per person by 2030. To do that, Tanzania needs 100,000 more tons of fish by 2025, and because the state’s aim is to produce this fish locally, the country’s fish farmers stand to benefit. Already, the government has been giving grants to people who want to start fish farming, as well as loaning fish cages to them. These farmers will need a lot of fish feed. “We believe that if the fish will feed the world, we must feed the fish,” Orembe says.
In the course of producing their feed, NovFeed discovered that they could use their methods to produce a more climate-friendly plant fertilizer, also made from discarded organic waste. They’ve so far managed to complete two fertilizers, with different efficiency rates. With the first one, which is already being sold to farmers, one needs to use five litres of the fertilizer for every acre of farmland. The second one, which is still waiting for approval from the state regulator before being sold, has produced spectacular results in testing. One litre of the fertilizer is enough for an acre of farmland.

With both the fish feed and the fertilizer, NovFeed’s plans to feed Tanzania by boosting local farmers, thus increasing food security in the country. In addition, they are tackling Dar es Salaam’s food waste problem, determined to not let the city succumb to its piles of garbage.









